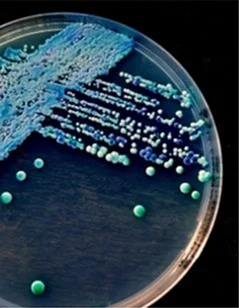

The urinary tract is responsible for producing and storing urine in the body. It consists of four parts: kidneys, ureters, bladder, and urethra. The kidneys remove excess water from the blood, which is converted into urine. Normally, urine does not contain bacteria. However, sometimes bacteria can enter the urinary system from outside and cause an infection and inflammation. This condition is known as a urinary tract infection.
To prevent Urinary Tract Infections, people are often prescribed a low dose of antibiotics.
Also Read: If Someone Is Having A Stroke: 3 Things To Do And 3 Things Not To Do
What is a UTI?
A Urinary Tract Infection (UTI) can occur in any part of the urinary tract, including the kidneys, ureters, bladder, and urethra. However, the infection is most commonly found in the bladder and urethra.
Studies have shown that women are more prone to Urinary Tract infections (UTIs) compared to men. The reason behind this is the shorter length of the urethra in women, which is closer to the anus. Bacteria are commonly found in the anus, leading to the likelihood of infection. Although women are more susceptible, men and children can also get UTIs.
Causes of a UTI
When bacteria enter the urinary tract through the urethra, it can lead to a Urinary Tract Infection (UTI) by spreading to the bladder. Although the urinary system is designed to prevent bacteria from entering, it may fail, resulting in an infection.
Women are more prone to UTIs, which typically affect the bladder or urethra. The infection is usually caused by Escherichia Coli, a bacteria commonly found in the gastrointestinal tract. However, other types of bacteria can also lead to UTIs.
Bladder infection is more commonly observed in women as it is easier for bacteria to enter their urinary system and spread to the bladder. Sexual activities are among the factors that can cause a bladder infection.
Urinary Tract Infection can spread to the urethra in women when bacteria enter the urinary tract. Sexual activity can also be a cause of this infection because the urethra in women is located closer to the vagina.
Symptoms of UTIs
UTIs can cause a range of symptoms, including:
- Pain in the abdomen or pelvic area
- Pressure in the pelvic area
- Frequent urge to urinate
- Inconsistent urine flow
- Painful urination and blood in urine
- Urgency to urinate at night
- Discoloration and foul odor of urine
- Pain during intercourse in women
- Penis pain in men
- Flank or lower back pain
- Fever, fatigue, and vomiting
- Brain fog and confusion
If you experience any of these symptoms, it is important to consult with a healthcare professional.
Also Read: Popping Cystic Acne: Can It Be Done?
Complications of Urinary Tract Infection
Untreated UTIs can lead to various complications, and some of them can even be life-threatening. It is crucial to seek medical attention if you experience any symptoms of a UTI to avoid potential risks.
Therefore, if you notice any of the symptoms, it is crucial to seek medical attention immediately. Here are some of the complications that may arise from a urinary tract infection.
- Untreated Urinary Tract Infections can lead to recurring infections and other complications.
- Poor hygiene practices can contribute to recurring UTIs.
- If left untreated, UTIs can progress to kidney infections, which can cause kidney failure.
- Pregnant women with UTIs may experience complications, including premature birth or kidney failure.
- Men with UTIs may experience prostatitis, swelling, and inflammation, but this can typically be treated with antibiotics.
- In severe cases, untreated UTIs can lead to sepsis, a life-threatening infection that can cause organ malfunction.
It is important to seek treatment for UTIs promptly to avoid these potential complications.
Treatment For Urinary Tract Infection
The initial and most frequently used treatment for Urinary Tract Infections is antibiotics. A physician may determine the appropriate medication and duration of treatment based on the specific infection and bacteria present in a patient's urine.
Trimethoprim, sulfamethoxazole, Fosfomycin, Nitrofurantoin, Cephalexin, and Ceftriaxone are among the medications commonly used to treat mild Urinary Tract Infections. However, in the case of severe UTIs or kidney infections, a physician may prescribe a class of antibiotics known as fluoroquinolones.
Physicians typically prescribe medications for uncomplicated Urinary Tract Infections for a duration of two to three days. In cases of frequent infections, low-dose antibiotics may be prescribed by the doctor.
In cases where the Urinary Tract Infection is caused by sexual activity, individuals may consider taking a dose of medication following sexual intercourse.
Symptoms of a Urinary Tract Infection typically diminish after a few days of treatment; however, it is important to continue taking the prescribed antibiotics for several weeks.
Preventions of Urinary Tract Infections
There are numerous preventive steps individuals can take to avoid Urinary Tract Infections. Here are a few preventive measures for UTIs:
- Cleanse your genitals before and after sexual activities using warm water and plain soap, avoiding scented soaps.
- Urinate immediately after sexual activity to flush bacteria from the urethra.
- Wash your rectum regularly.
- Drink plenty of water.
- Avoid holding your urine.
- Women should avoid douching and opt for showers instead of baths.
- Avoid using harsh or scented soaps around the genital area.
- Use condoms during sexual activity to help prevent infections.
- Wear cotton underwear to prevent infections.
Incorporating these preventive measures into your daily routine can help reduce the risk of developing a Urinary Tract Infection.
Also Read: Post-Breast Cancer Surgery Recovery Tips: What to Expect After Your Operation
Conclusion
Urinary Tract Infections can impact any organ within the urinary system. To avoid such infections, individuals should adhere to recommended precautions. In cases of severe symptoms, it is imperative to seek medical attention immediately. Additionally, it is highly recommended to follow all prescribed medications provided by a medical professional.

%20(1).jpg)
%20(1).png)
.png)
%20(1).png)


%20(1).png)




%201.png)
